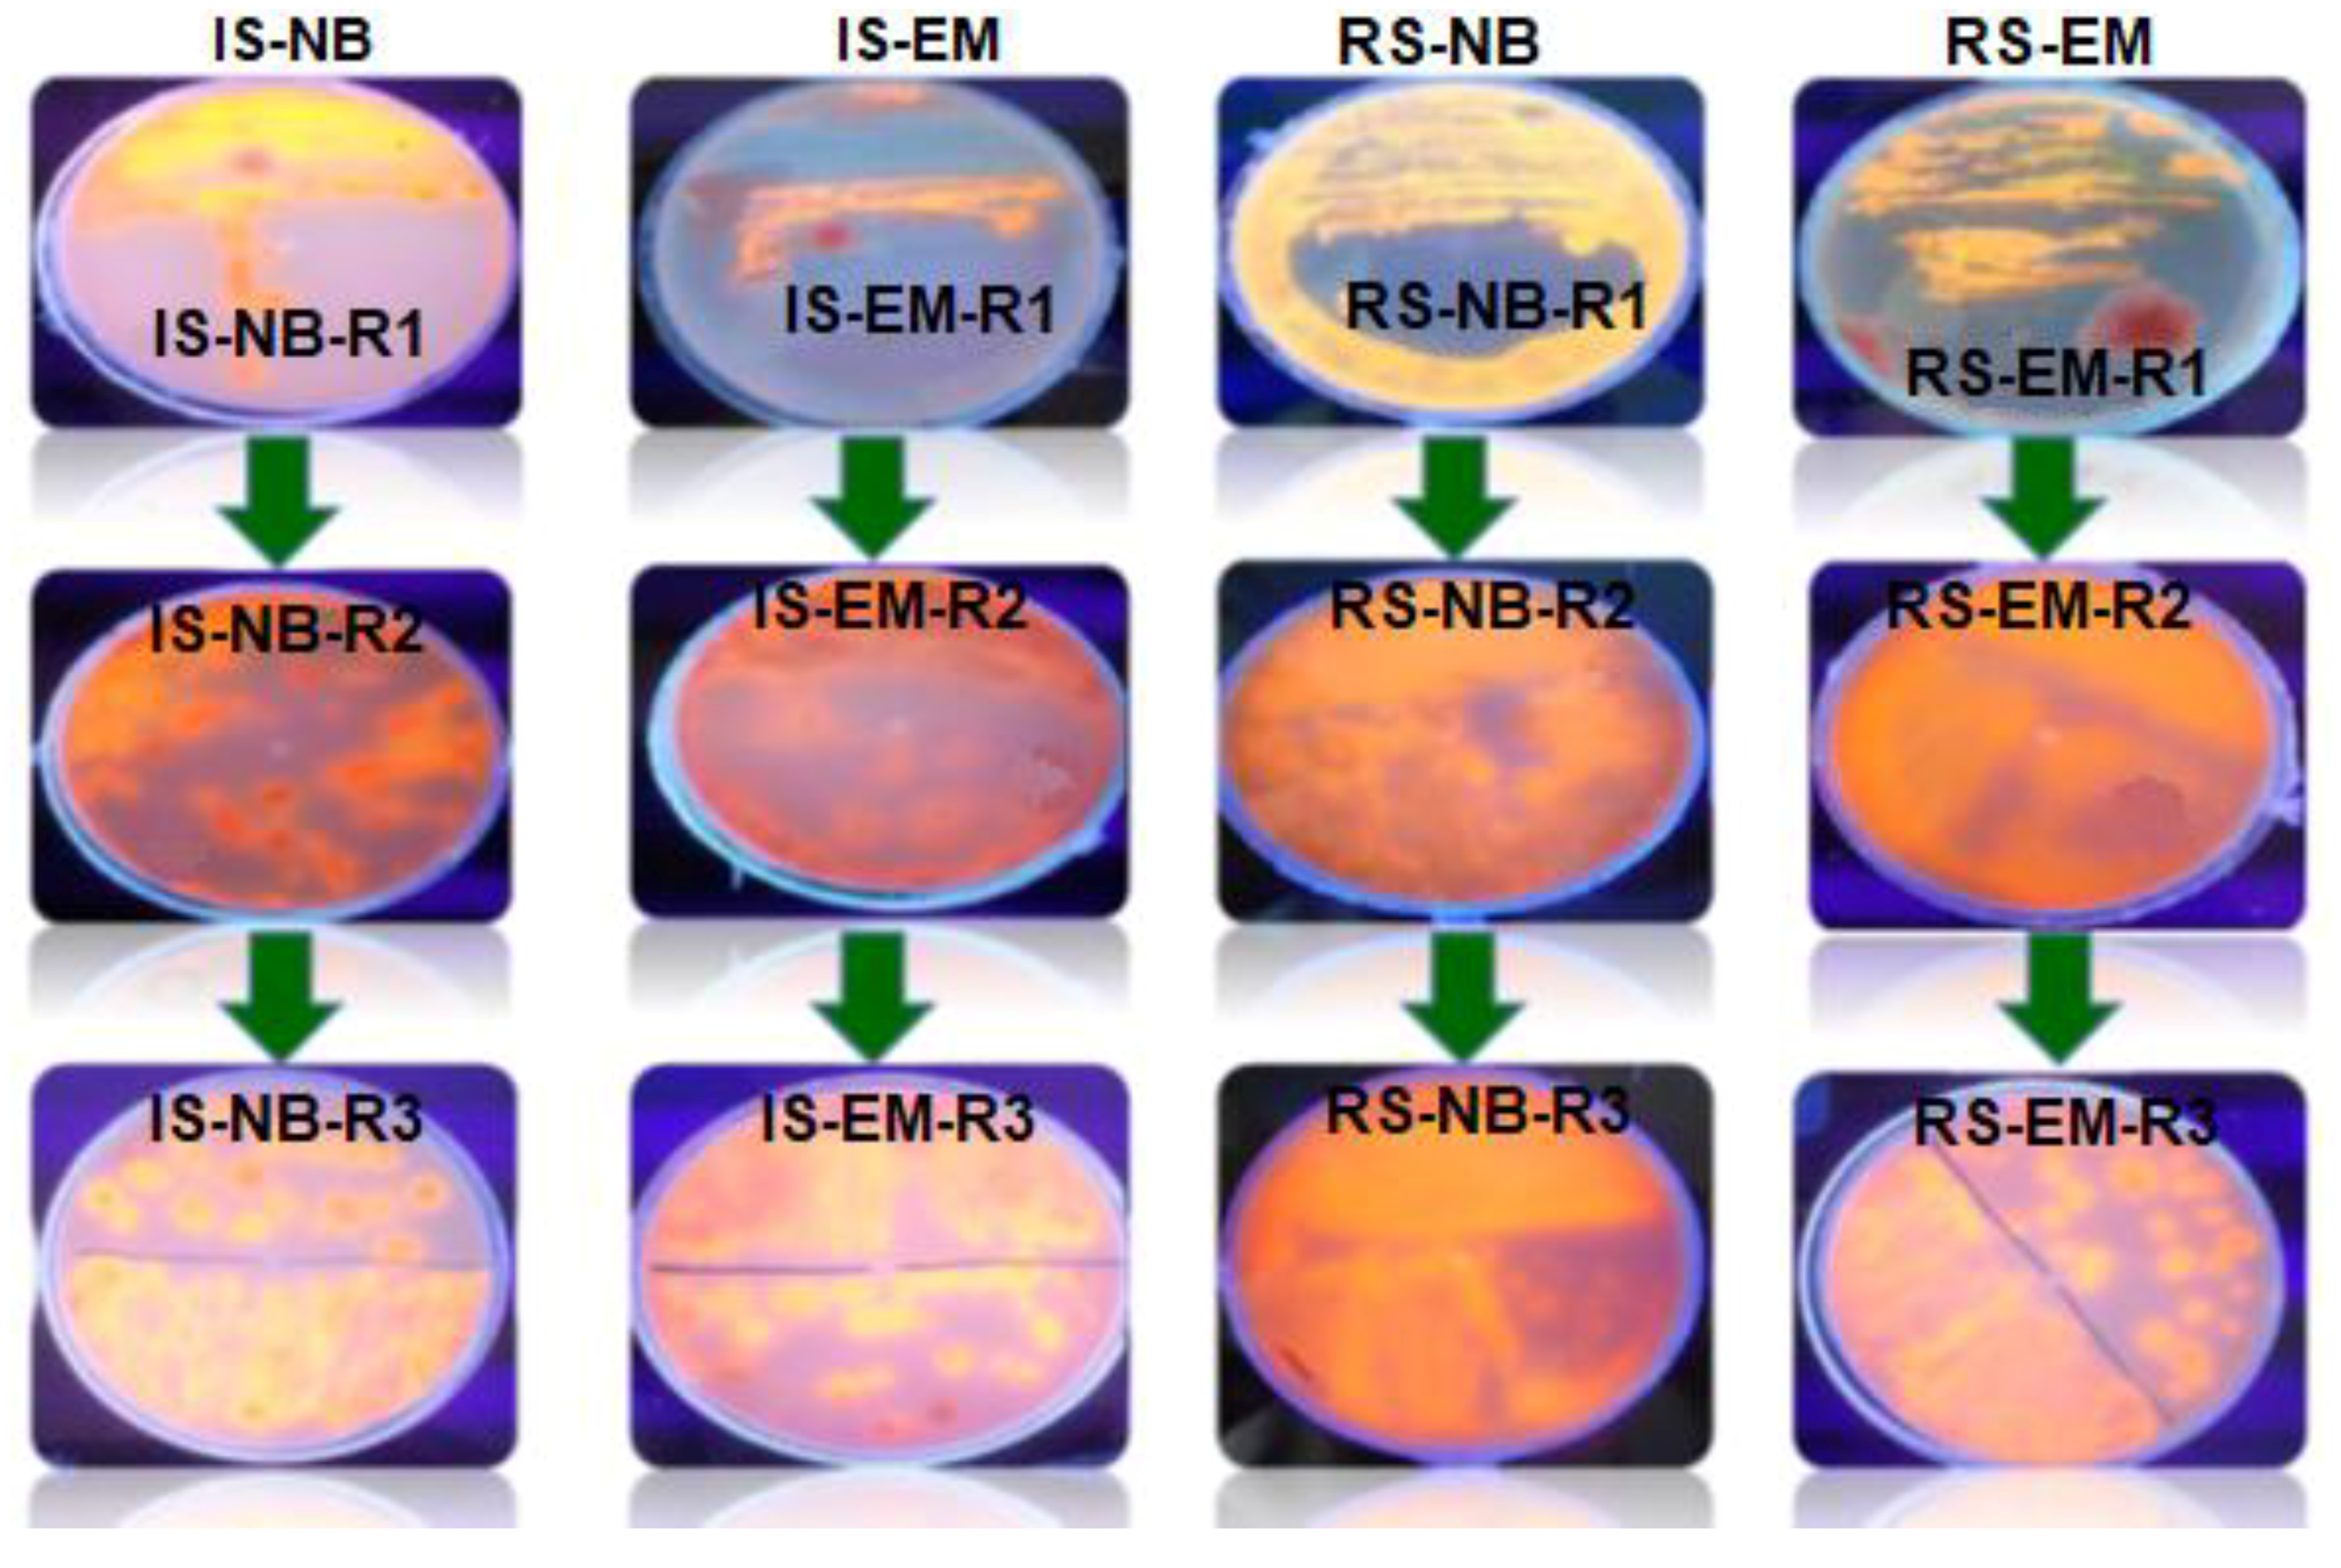
Water 12 02172 g003 Water 12 02172 g003
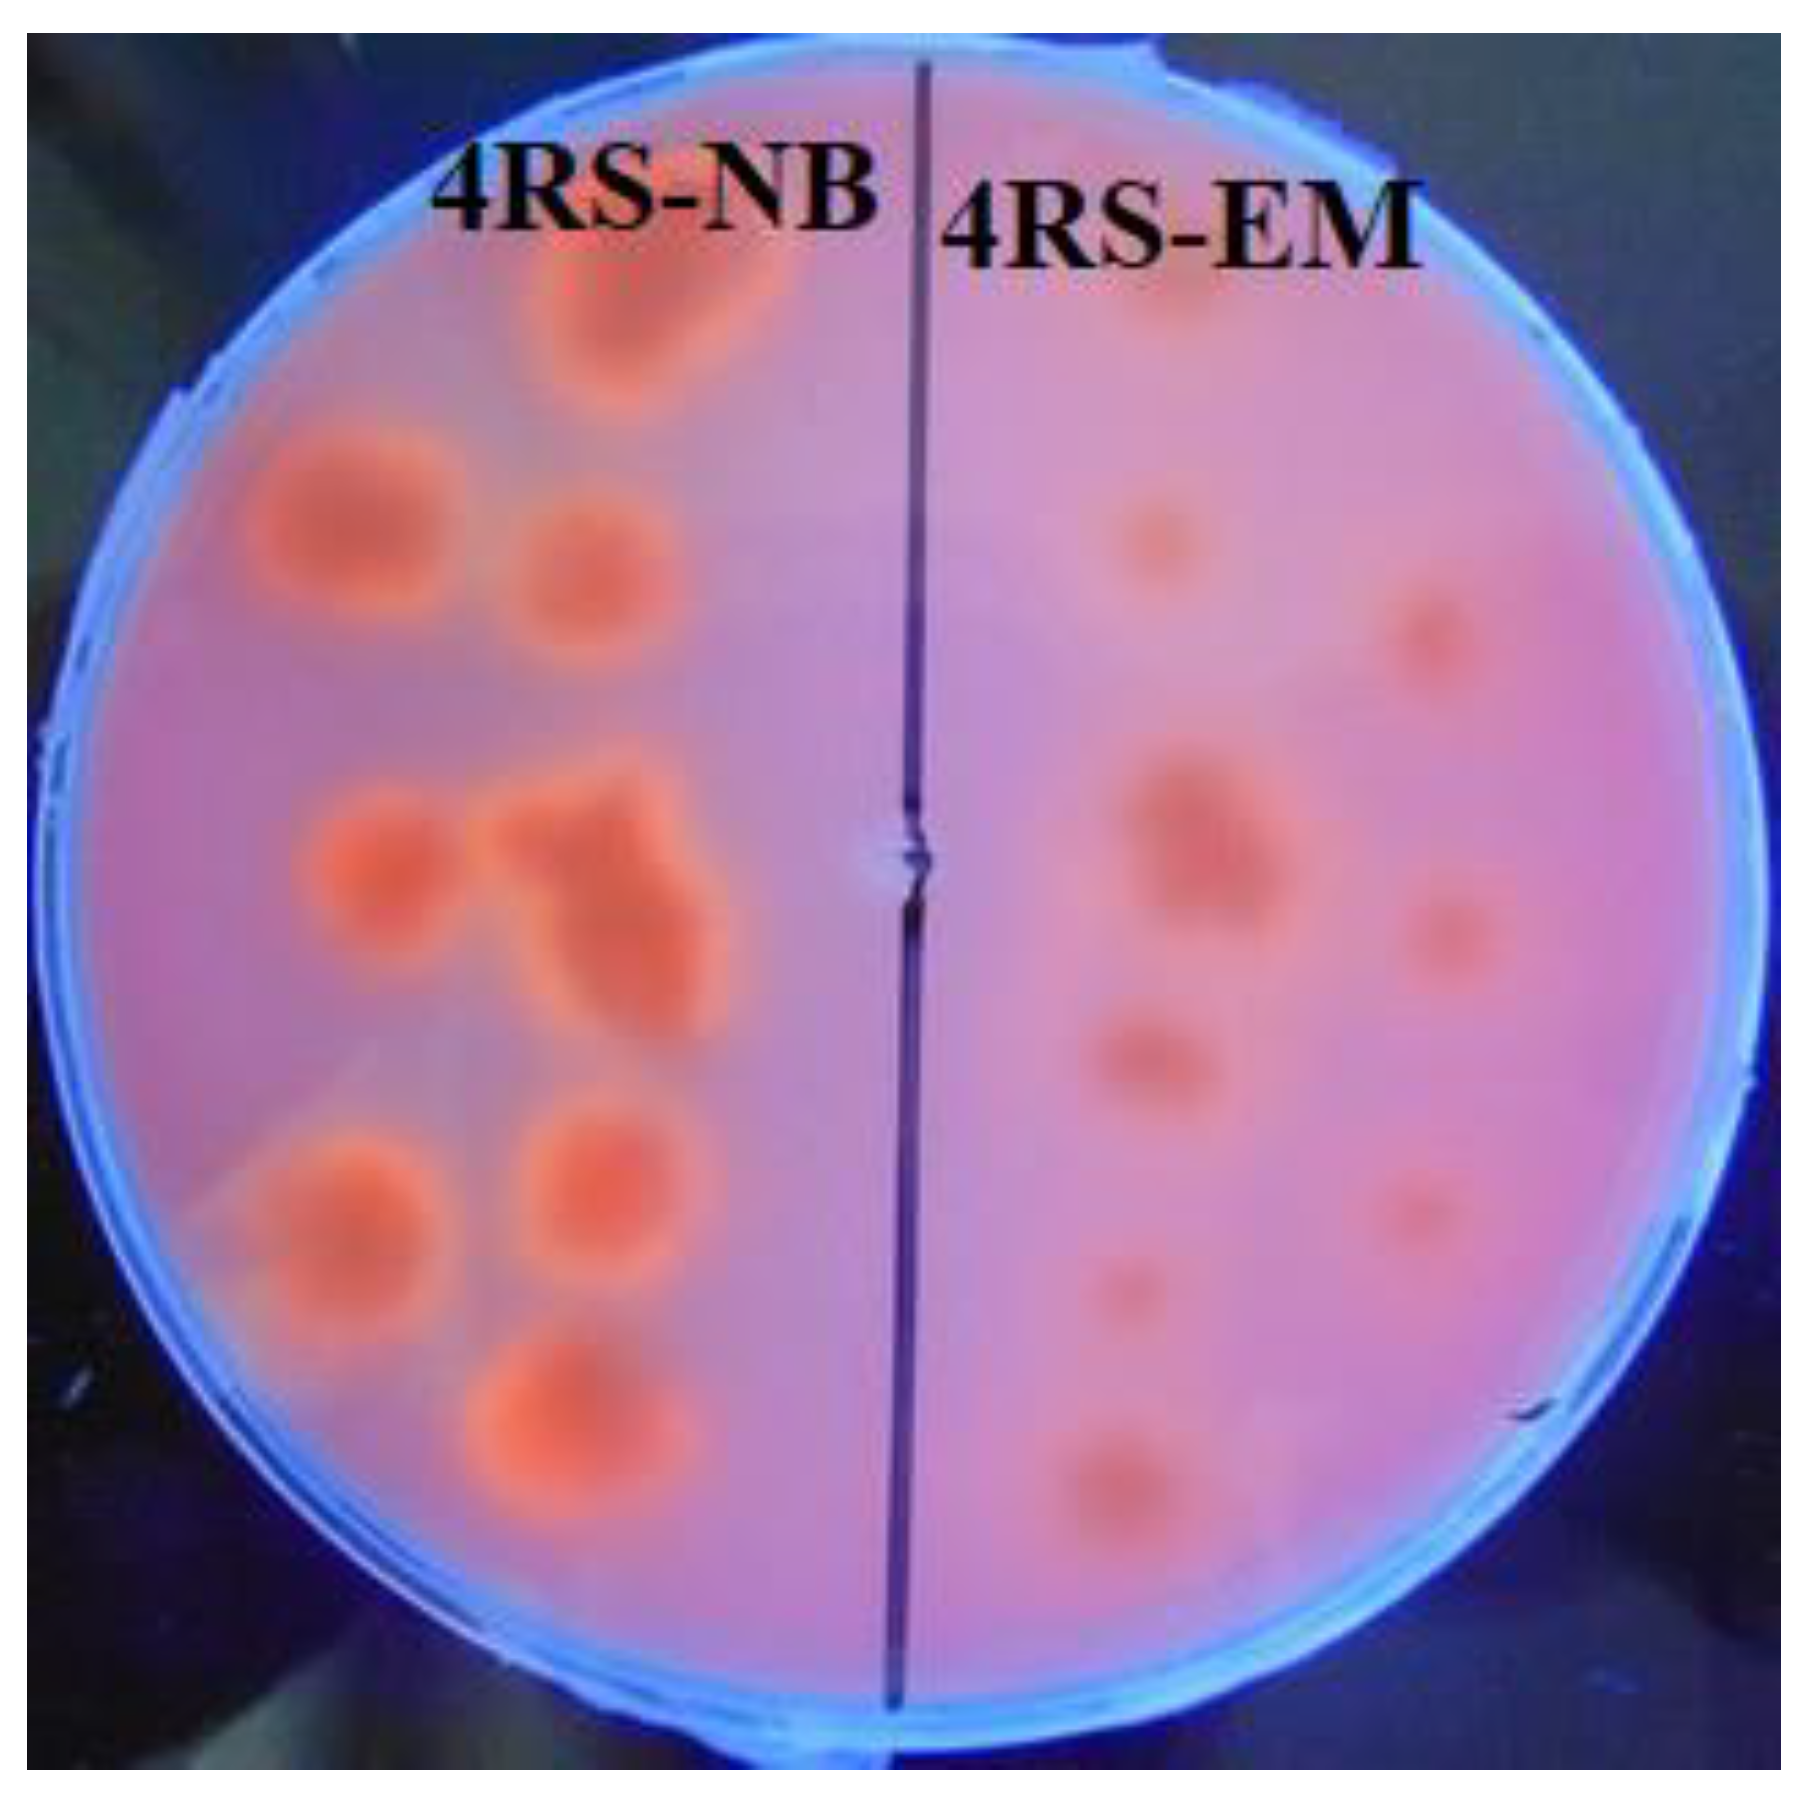
Water 12 02172 g004 Water 12 02172 g004

Characterization of Thermophilic Microorganisms in the Geothermal Water Flow of El Chichón Volcano Crater Lake
Abstract
1. Introduction
2. Materials and Methods
2.1. Site Description and Sample Collection
2.2. Cultivation of the Thermophilic Microorganisms
2.3. Isolation of Lipase-Producing Thermophilic Microorganisms
2.4. Identification of Lipase-Producing Bacteria
2.4.1. Molecular Identification
2.4.2. Morphologic and Biochemical Characterization
2.4.3. Growth of Lipase-Producing Thermophilic Microorganisms and Enzymatic Activity Determination
3. Results and Discussion
3.1. Cultivation of the Thermophilic Microorganisms
3.2. Isolation and Identification of Lipase-Producing Thermophilic Microorganisms
3.3. Molecular Identification of Lipase-Producing Thermophilic Microorganisms
3.4. Morphologic and Biochemical Characterization of G. jurassicus CHI2 and G. stearothermophilus CHI1
3.5. Microbial Growth and Extracellular Lipolytic Activity of G. stearothermophilus CHI1
4. Conclusions
Author Contributions
Funding
Acknowledgments
Conflicts of Interest
References
- Gutiérrez-Arnillas, E.; Rodríguez, A.; Sanromán, M.A.; Deive, F.J. New sources of halophilic lipases: Isolation of bacteria from Spanish and Turkish saltworks. Biochem. Eng. J. 2016, 109, 170–177. [Google Scholar] [CrossRef]
- Woodley, J.M. Protein engineering of enzymes for process applications. Curr. Opin. Chem. Biol. 2013, 17, 310–316. [Google Scholar] [CrossRef] [PubMed]
- Gomes, J.; Steiner, W. The biocatalytic potential of extremophiles and extremozymes. Food Technol. Biotechnol. 2004, 42, 223–235. [Google Scholar]
- Elleuche, S.; Schäfers, C.; Blank, S.; Schröder, C.; Antranikian, G. Exploration of extremophiles for high temperature biotechnological processes. Curr. Opin. Microbiol. 2015, 25, 113–119. [Google Scholar] [CrossRef]
- Rothschild, L.J.; Mancinelli, R.L. Life in extreme environments. Nature 2001, 409, 1092–1101. [Google Scholar] [CrossRef]
- Elleuche, S.; Schröder, C.; Sahm, K.; Antranikian, G. Extremozymes—biocatalysts with unique properties from extremophilic microorganisms. Curr. Opin. Biotechnol. 2014, 29, 116–123. [Google Scholar] [CrossRef]
- Bergquist, P.L.; Morgan, H.W.; Saul, D. Selected enzymes from extreme thermophiles with applications in biotechnology. Curr. Biotechnol. 2014, 3, 45–59. [Google Scholar] [CrossRef]
- Fütterer, O.; Angelov, A.; Liesegang, H.; Gottschalk, G.; Schleper, C.; Schepers, B. Genome sequence of Picrophilus torridus and its implications for life around pH 0. Proc. Natl. Acad. Sci. USA 2004, 101, 9091–9096. [Google Scholar] [CrossRef]
- Giaveno, M.A.; Urbieta, M.S.; Ulloa, J.R.; González Toril, E.; Donati, E.R. Physiologic versatility and growth flexibility as the main characteristics of a novel thermoacidophilic acidianus strain isolated from copahue geothermal area in argentina. Microb. Ecol. 2013, 65, 336–346. [Google Scholar] [CrossRef]
- Urbieta, M.S.; Toril, E.G.; Giaveno, M.A.; Bazán, A.A.; Donati, E.R. Archaeal and bacterial diversity in five different hydrothermal ponds in the Copahue region in Argentina. Syst. Appl. Microbiol. 2014, 37, 429–441. [Google Scholar] [CrossRef]
- Amin, A.; Ahmed, I.; Khalid, N.; Zhang, Y.; Xiao, M.; Li, W.J. Insights into the thermophile diversity in hot springs of pakistan. In Extremophiles in Eurasian Ecosystems: Ecology, Diversity, and Applications; Springer: Singapore, 2018; Volume 8, pp. 1–28. [Google Scholar]
- Ansari, I.; Kumar, R.; Sundararajan, M.; Maiti, D.; Rather, M.A.; Ali, M. Investigation on growth of oil degrading thermophilic bacteria isolated from hot spring. Biosci. Biotechnol. Res. Asia 2018, 15, 805–815. [Google Scholar] [CrossRef]
- Slobodkina, G.B.; Baslerov, R.V.; Kostryukova, N.K.; Bonch-Osmolovskaya, E.A.; Slobodkin, A.I. Tepidibaculum saccharolyticum gen. nov., sp. nov. a moderately thermophilic, anaerobic, spore-forming bacterium isolated from a terrestrial hot spring. Extremophiles 2018, 22, 761–768. [Google Scholar] [CrossRef] [PubMed]
- Urbieta, M.S.; Donati, E.R.; Chan, K.G.; Shahar, S.; Sin, L.L.; Goh, K.M. Thermophiles in the genomic era: Biodiversity, science, and applications. Biotechnol. Adv. 2015, 33, 633–647. [Google Scholar] [CrossRef] [PubMed]
- Bendia, A.G.; Araujo, G.G.; Pulschen, A.A.; Contro, B.; Duarte, R.T.D.; Rodrigues, F. Surviving in hot and cold: Psychrophiles and thermophiles from deception island volcano, antarctica. Extremophiles 2018, 22, 917–929. [Google Scholar] [CrossRef] [PubMed]
- Simanjuntak, S.; Samuel, M.Y. Isolation and identification of thermophilic bacteria, producer of amylase enzyme, from lake linow, north sulawesi. J. Pure Appl. Microbiol. 2018, 12, 543–554. [Google Scholar] [CrossRef]
- Santana, M.M.; Gonzalez, J.M. High temperature microbial activity in upper soil layers. FEMS Microbiol. Lett. 2015, 362. [Google Scholar] [CrossRef]
- Rastogi, G.; Bhalla, A.; Adhikari, A.; Bischoff, K.M.; Hughes, S.R.; Christopher, L.P.; Sani, R.K. Characterization of thermostable cellulases produced by Bacillus and Geobacillus strains. Bioresour. Technol. 2010, 101, 8798–8806. [Google Scholar] [CrossRef]
- Kim, H.; Lee, J.Y. Effects of a groundwater heat pump on thermophilic bacteria activity. Water 2019, 11, 2084. [Google Scholar] [CrossRef]
- Kor-Bicakci, G.; Ubay-Cokgor, E.; Eskicioglu, C. Comparative analysis of bacterial and archaeal community structure in microwave pretreated thermophilic and mesophilic anaerobic digesters utilizing mixed sludge under organic overloading. Water 2020, 12, 887. [Google Scholar] [CrossRef]
- Chen, X.; Wu, Y.; Zeng, L. Migration of gyrotactic micro-organisms in water. Water 2018, 10, 1455. [Google Scholar] [CrossRef]
- Zerva, I.; Remmas, N.; Ntougias, S. Diversity and biotechnological potential of xylan-degrading microorganisms from orange juice processing waste. Water 2019, 11, 274. [Google Scholar] [CrossRef]
- Guerrero-Barajas, C.; Ordaz, A.; Garibay-Orijel, C.; García-Solares, S.M.; Bastida-González, F.; Zárate-Segura, P.B. Enhanced sulfate reduction and trichloroethylene (TCE) biodegradation in a UASB reactor operated with a sludge developed from hydrothermal vents sediments: Process and microbial ecology. Int. Biodeter. Biodegr. 2014, 94, 182–191. [Google Scholar] [CrossRef]
- Ilyas, S.; Lee, J.C.; Kim, B.S. Bioremoval of heavy metals from recycling industry electronic waste by a consortium of moderate thermophiles: Process development and optimization. J. Clean. Prod. 2014, 70, 194–202. [Google Scholar] [CrossRef]
- Sen, S.K.; Raut, S.; Dora, T.K.; Mohapatra, P.K.D. Contribution of hot spring bacterial consortium in cadmium and lead bioremediation through quadratic programming model. J. Hazard. Mater. 2014, 265, 47–60. [Google Scholar] [CrossRef]
- Talluri, S.; Raj, S.M.; Christopher, L.P. Consolidated bioprocessing of untreated switchgrass to hydrogen by the extreme thermophile Caldicellulosiruptor saccharolyticus DSM 8903. Bioresour. Technol. 2013, 139, 272–279. [Google Scholar] [CrossRef]
- Lavania, M.; Cheema, S.; Sarma, P.M.; Ganapathi, R.; Lal, B. Methanogenic potential of a thermophilic consortium enriched from coal mine. Int. Biodeter. Biodegr. 2014, 93, 177–185. [Google Scholar] [CrossRef]
- Li, X.; Qian, P.; Wu, S.G.; Yu, H.Y. Characterization of an organic solvent-tolerant lipase from Idiomarina sp. W33 and its application for biodiesel production using Jatropha oil. Extremophiles 2014, 18, 171–178. [Google Scholar] [CrossRef]
- Abdollahi, H.; Shafaei, S.Z.; Noaparast, M.; Manafi, Z.; Niemelä, S.I.; Tuovinen, O.H. Mesophilic and thermophilic bioleaching of copper from a chalcopyrite-containing molybdenite concentrate. Int. J. Miner. Process. 2014, 128, 25–32. [Google Scholar] [CrossRef]
- Li, S.; Zhong, H.; Hu, Y.; Zhao, J.; He, Z.; Gu, G. Bioleaching of a low-grade nickel–copper sulfide by mixture of four thermophiles. Bioresour. Technol. 2014, 153, 300–306. [Google Scholar] [CrossRef]
- Bharali, P.; Das, S.; Konwar, B.K.; Thakur, A.J. Crude biosurfactant from thermophilic Alcaligenes faecalis: Feasibility in petro-spill bioremediation. Int. Biodeterior. Biodegr. 2011, 65, 682–690. [Google Scholar] [CrossRef]
- Adiguzel, A.; Ozkan, H.; Baris, O.; Inan, K.; Gulluce, M.; Sahin, F. Identification and characterization of thermophilic bacteria isolated from hot springs in Turkey. J. Microbiol. Methods 2009, 79, 321–328. [Google Scholar] [CrossRef] [PubMed]
- Bhalla, A.; Bansal, N.; Kumar, S.; Bischoff, K.M.; Sani, R.K. Improved lignocellulose conversion to biofuels with thermophilic bacteria and thermostable enzymes. Bioresour. Technol. 2013, 128, 751–759. [Google Scholar] [CrossRef] [PubMed]
- Goh, K.M.; Kahar, U.M.; Chai, Y.Y.; Chong, C.S.; Chai, K.P.; Ranjani, V. Recent discoveries and applications of Anoxybacillus. Appl. Microbiol. Biotechnol. 2013, 97, 1475–1488. [Google Scholar] [CrossRef] [PubMed]
- Chai, Y.Y.; Rahman, R.N.Z.R.A.; Illias, R.M.; Goh, K.M. Cloning and characterization of two new thermostable and alkalitolerant α-amylases from the Anoxybacillus species that produce high levels of maltose. J. Ind. Microbiol. Biotechnol. 2012, 39, 731–741. [Google Scholar] [CrossRef] [PubMed]
- Van den Burg, B. Extremophiles as a source for novel enzymes. Curr. Opin. Microbiol. 2003, 6, 213–218. [Google Scholar] [CrossRef]
- Bornscheuer, U.T. Microbial carboxyl esterases: Classification, properties and application in biocatalysis. FEMS Microbiol. Rev. 2002, 26, 73–81. [Google Scholar] [CrossRef] [PubMed]
- Hasan, F.; Shah, A.A.; Hameed, A. Industrial applications of microbial lipases. Enzym. Microb. Technol. 2006, 39, 235–251. [Google Scholar] [CrossRef]
- Houde, A.; Kademi, A.; Leblanc, D. Lipases and their industrial applications. Appl.Biochem. Biotechnol. 2004, 118, 155–170. [Google Scholar] [CrossRef]
- Ray, A. Application of lipase in industry. Asian J. Pharm. Tech. 2012, 2, 33–37. [Google Scholar]
- Tacias-Pascacio, V.G.; Virgen-Ortíz, J.J.; Jiménez-Pérez, M.; Yates, M.; Torrestiana-Sanchez, B.; Rosales-Quintero, A.; Fernandez-Lafuente, R. Evaluation of different lipase biocatalysts in the production of biodiesel from used cooking oil: Critical role of the immobilization support. Fuel 2017, 200, 1–10. [Google Scholar] [CrossRef]
- Tacias-Pascacio, V.G.; Torrestiana-Sánchez, B.; Dal Magro, L.; Virgen-Ortíz, J.J.; Suárez-Ruíz, F.J.; Rodrigues, R.C.; Fernandez-Lafuente, R. Comparison of acid, basic and enzymatic catalysis on the production of biodiesel after RSM optimization. Renew. Energy 2019, 135, 1–9. [Google Scholar] [CrossRef]
- Salihu, A.; Alam, M.Z.; AbdulKarim, M.I.; Salleh, H.M. Lipase production: An insight in the utilization of renewable agricultural residues. Resour. Conserv. Recycl. 2012, 58, 36–44. [Google Scholar] [CrossRef]
- Watanabe, Y.; Shimada, Y.; Sugihara, A.; Noda, H.; Fukuda, H.; Tominaga, Y. Continuous production of biodiesel fuel from vegetable oil using immobilized Candida antarctica lipase. J. Amer. Oil Chem. Soc. 2000, 77, 355–360. [Google Scholar] [CrossRef]
- Hantsis-Zacharov, E.; Halpern, M. Culturable psychrotrophic bacterial communities in raw milk and their proteolytic and lipolytic traits. Appl. Environ. Microbiol. 2007, 73, 7162–7168. [Google Scholar] [CrossRef] [PubMed]
- Sirisha, E.; Rajasekar, N.; Narasu, M.L. Isolation and optimization of lipase producing bacteria from oil contaminated soils. Adv. Biol. Res. 2010, 4, 249–252. [Google Scholar]
- Veerapagu, M.; Narayanan, A.S.; Ponmurugan, K.; Jeya, K.R. Screening selection identification production and optimization of bacterial lipase from oil spilled soil. Asian J. Pharm. Clin. Res. 2013, 6, 62–67. [Google Scholar]
- Bharathi, D.; Rajalakshmi, G.; Komathi, S. Optimization and production of lipase enzyme from bacterial strains isolated from petrol spilled soil. J. King Saud Univ. Sci. 2019, 31, 898–901. [Google Scholar] [CrossRef]
- Armienta, M.A.; Vilaclara, G.; De la Cruz-Reyna, S.; Ramos, S.; Ceniceros, N.; Cruz, O. Water chemistry of lakes related to active and inactive mexican volcanoes. J. Volcanol. Geotherm. Res. 2008, 178, 249–258. [Google Scholar] [CrossRef]
- Casas, A.S.; Armienta, M.A.; Ramos, S. Sulfur speciation with high performance liquid chromatography as a tool for El Chichón volcano, crater lake monitoring. J. S. Am. Earth Sci. 2016, 72, 241–249. [Google Scholar] [CrossRef]
- Contreras, U.A.; Salgado, E.J. Evaluación geológico-estructural del complejo volcánico chichonal, chiapas, como fuente alterna de energía. Geotermia 2012, 25, 3–20. [Google Scholar]
- Cuoco, E.; De Francesco, S.; Tedesco, D. Hydrogeochemical dynamics affecting steam-heated pools at El Chichón crater (Chiapas–Mexico). Geofluids 2013, 13, 331–343. [Google Scholar] [CrossRef]
- Armienta, M.A.; De La Cruz-Reyna, S.; Ramos, S.; Ceniceros, N.; Cruz, O.; Aguayo, A.; Arcega-Cabrera, F. Hydrogeochemical surveillance at El Chichón volcano crater lake, Chiapas, Mexico. J. Volcanol. Geotherm. Res. 2014, 285, 118–128. [Google Scholar] [CrossRef]
- Taran, Y.A.; Peiffer, L. Hydrology, hydrochemistry and geothermal potential of El Chichón volcano-hydrothermal system, Mexico. Geothermics 2009, 38, 370–378. [Google Scholar] [CrossRef]
- Mazot, A.; Rouwet, D.; Taran, Y.; Inguaggiato, S.; Varley, N. CO2 and he degassing at El Chichón volcano, chiapas, mexico: Gas flux, origin and relationship with local and regional tectonics. Bull. Volcanol. 2011, 73, 423–441. [Google Scholar] [CrossRef]
- Paz, M.P.J.; Taran, Y.; Inguaggiato, S.; Collard, N. CO2 flux and chemistry of El Chichón crater lake (México) in the period 2013–2015: Evidence for the enhanced volcano activity. Geophys. Res. Lett. 2016, 43, 127–134. [Google Scholar]
- Rincón-Molina, C.I.; Hernández-García, J.A.; Rincón-Rosales, R.; Gutiérrez-Miceli, F.A.; Ramírez-Villanueva, D.A.; González-Terreros, E.; Peña-Ocaña, B.A. Structure and diversity of the bacterial communities in the acid and thermophilic crater-lake of the volcano “El Chichón”, mexico. Geomicrobiol. J. 2019, 36, 97–109. [Google Scholar] [CrossRef]
- Rincón-Molina, C.I.; Martínez-Romero, E.; Ruiz-Valdiviezo, V.M.; Velázquez, E.; Ruiz-Lau, N.; Rogel-Hernández, M.A. Plant growth-promoting potential of bacteria associated to pioneer plants from an active volcanic site of Chiapas (Mexico). Appl. Soil Ecol. 2020, 146, 103390. [Google Scholar] [CrossRef]
- Lee, D.; Koh, Y.; Kim, K.; Kim, B.; Choi, H.; Kim, D. Isolation and characterization of a thermophilic lipase from bacillus thermoleovorans ID-1. FEMS Microbiol. Lett. 1999, 179, 393–400. [Google Scholar] [CrossRef]
- Berekaa, M.M.; Zaghloul, T.I.; Abdel-Fattah, Y.R.; Saeed, H.M.; Sifour, M. Production of a novel glycerol-inducible lipase from thermophilic Geobacillus stearothermophilus strain-5. World J. Microbiol. Biotechnol. 2009, 25, 287–294. [Google Scholar] [CrossRef]
- Kouker, G.; Jaeger, K.E. Specific and sensitive plate assay for bacterial lipases. Appl. Environ. Microbiol. 1987, 53, 211. [Google Scholar] [CrossRef]
- Hou, C.T. PH dependence and thermostability of lipases from cultures from the ARS culture collection. J. Ind. Microbiol. 1994, 13, 242–248. [Google Scholar] [CrossRef]
- Ruiz-Romero, E.; Coutino-Coutino Mde, L.; Valenzuela-Encinas, C.; Lopez-Ramirez, M.P.; Marsch, R.; Dendooven, L. Texcoconibacillus texcoconensis gen. nov., sp. nov., alkalophilic and halotolerant bacteria isolated from soil of the former lake Texcoco (Mexico). Int. J. Syst. Evol. Microbiol. 2013, 63, 3336–3341. [Google Scholar] [CrossRef] [PubMed]
- Larkin, M.A.; Blackshields, G.; Brown, N.P.; Chenna, R.; Mc Gettigan, P.A.; Mc William, H.; Valentin, F.; Wallace, I.M.; Wilm, A.; Lopez, R.; et al. Clustal W and Clustal X version 2.0. Bioinformatics 2007, 23, 2947–2948. [Google Scholar] [CrossRef] [PubMed]
- Tamura, K.; Peterson, D.; Peterson, N.; Stecher, G.; Nei, M.; Kumar, S. MEGA 5: Molecular evolutionary genetics analysis using maximum likelihood, evolutionary distance, and maximum parsimony methods. Mol. Biol. Evol. 2011, 28, 2731–2739. [Google Scholar] [CrossRef]
- Saitou, N.; Nei, M. The neighbor-joining method: A new method for reconstructing phylogenetic trees. Mol. Biol. Evol. 1987, 4, 406–425. [Google Scholar]
- Tamura, K.; Nei, M. Estimation of the number of nucleotide substitutions in the control region of mitochondrial DNA in humans and chimpanzees. Mol. Biol. Evol. 1993, 10, 512–526. [Google Scholar]
- Nazina, T.N.; Sokolova, D.S.; Grigoryan, A.A.; Shestakova, N.M.; Mikhailova, E.M.; Poltaraus, A.B. Geobacillus jurassicus sp. nov., a new thermophilic bacterium isolated from a high-temperature petroleum reservoir, and the validation of the Geobacillus species. Syst. Appl. Microbiol. 2005, 28, 43–53. [Google Scholar] [CrossRef]
- Mohan, S.K. Gram Stain: Looking Beyond Bacteria to Find Fungi in Gram Stained Smear: A Laboratory Guide for Medical Microbiology; AuthorHouse: Bloomington, IN, USA, 2009. [Google Scholar]
- Poppe, J.K.; Costa, A.P.O.; Brasil, M.C.; Rodrigues, R.C.; Ayub, M.A.Z. Multipoint covalent immobilization of lipases on aldehyde-activated support: Characterization and application in transesterification reaction. J. Mol. Catal. B Enzym. 2013, 94, 57–62. [Google Scholar] [CrossRef]
- Huber, R.; Huber, H.; Stetter, K.O. Towards the ecology of hyperthermophiles: Biotopes, new isolation strategies and novel metabolic properties. FEMS Microbiol. Rev. 2000, 24, 615–623. [Google Scholar] [CrossRef][Green Version]
- Tomova, I.; Lazarkevich, I.; Tomova, A.; Kambourova, M.; Vasileva-Tonkova, E. Diversity and biosynthetic potential of culturable aerobic heterotrophic bacteria isolated from Magura Cave, Bulgaria. Int. J. Speleol. 2013, 42, 65–76. [Google Scholar] [CrossRef]
- Tomova, I.; Gladka, G.; Tashyrev, A.; Vasileva-Tonkova, E. Isolation, identification and hydrolytic enzymes production of aerobic heterotrophic bacteria from two Antarctic islands. Int. J. Environ. Sci. 2014, 4, 614–625. [Google Scholar]
- Nazina, T.N.; Tourova, T.P.; Poltaraus, A.B.; Novikova, E.V.; Grigoryan, A.A.; Ivanova, A.E. Taxonomic study of aerobic thermophilic bacilli: Descriptions of Geobacillus subterraneus gen. nov., sp. nov. and Geobacillus uzenensis sp. nov. from petroleum reservoirs and transfer of Bacillus stearothermophilus, Bacillus thermocatenulatus, Bacillus thermoleovorans, Bacillus kaustophilus, Bacillus thermodenitrificans to Geobacillus as the new combinations G. stearothermophilus, G. th. Int. J. Syst. Evol. Microbiol. 2001, 51, 433–446. [Google Scholar] [PubMed]
- Blanchard, K.; Robic, S.; Matsumura, I. Transformable facultative thermophile Geobacillus stearothermophilus NUB3621 as a host strain for metabolic engineering. Appl. Microbiol. Biotechnol. 2014, 98, 6715–6723. [Google Scholar] [CrossRef] [PubMed]
- Qu, G.-R.; Xin, P.-Y.; Niu, H.-Y.; Jin, X.; Guo, X.-T.; Yang, X.-N.; Guo, H.-M. Microwave promoted palladium-catalyzed Suzuki–Miyaura cross-coupling reactions of 6-chloropurines with sodium tetraarylborate in water. Tetrahedron 2011, 67, 9099–9103. [Google Scholar] [CrossRef]
- Priest, F.G.; Alexander, B. A frequency matrix for probabilistic identification of some bacilli. J. Gen. Microbiol. 1988, 134, 3011–3018. [Google Scholar] [CrossRef]
- Sara, M.; Sleytr, U.B. S-layer proteins. J. Bacteriol. 2000, 182, 859–868. [Google Scholar] [CrossRef]
- Abdel-Fattah, Y.R. Optimization of thermostable lipase production from a thermophilic Geobacillus sp. using Box-Behnken experimental design. Biotechnol. Lett. 2002, 24, 1217–1222. [Google Scholar] [CrossRef]
- Mehta, A.; Saun, N.K.; Gupta, R. Purification and characterization of lipase from thermophilic Geobacillus sp. Curr. Biotechnol. 2016, 5, 81–89. [Google Scholar] [CrossRef]
- Christopher, L.P.; Zambare, V.P.; Zambare, A.; Kumar, H.; Malek, L. A thermo-alkaline lipase from a new thermophile Geobacillus thermodenitrificans AV-5 with potential application in biodiesel production. J. Chem. Technol. Biotechnol. 2015, 90, 2007–2016. [Google Scholar] [CrossRef]
- Kumar, S.; Kikon, K.; Upadhyay, A.; Kanwar, S.S.; Gupta, R. Production, purification, and characterization of lipase from thermophilic and alkaliphilic Bacillus coagulans BTS-3. Protein Expr. Purif. 2005, 41, 38–44. [Google Scholar] [CrossRef]

| Biochemical Test | Geobacillus jurassicus [68] | Geobacillus stearothermophilus [74,77] | Geobacillus jurassicus CHI2 | Geobacillus stearothermophilus CHI1 |
|---|---|---|---|---|
| Gram stain | + | ± | + | - |
| Lactose | - | - | - | - |
| Mannitol | + | ± | - | + |
| Raffinose | - | - | - | - |
| Maltose | + | + | + | + |
| Fructose | + | + | + | + |
| Starch | + | + | + | + |
| Casein | - | ± | + | - |
| C. Simmons | - | ± | - | - |
| Voges Proskauer | - | - | - | - |
| Methyl red | - | ± | - | - |
| Urease | - | - | - | - |
| MIO | ||||
| Motility | + | + | + | + |
| Ornithine decarboxylation | + | + | + | + |
| Indol | - | - | - | - |
| Production of H2S | - | - | - | - |
| TSI | ||||
| Glucose | - | - | - | - |
| Lactose | - | - | - | - |
| Sucrose | + | - | + | - |
| LIA | ||||
| Lysine decarboxylation | - | - | - | - |
| Lysine deamination | - | - | - | - |
| SIM | ||||
| Motility | + | + | + | + |
| Indole | - | - | - | - |
| Production of H2S | - | - | - | - |
© 2020 by the authors. Licensee MDPI, Basel, Switzerland. This article is an open access article distributed under the terms and conditions of the Creative Commons Attribution (CC BY) license (http://creativecommons.org/licenses/by/4.0/).
Share and Cite
Ovando-Chacon, S.L.; Tacias-Pascacio, V.G.; Ovando-Chacon, G.E.; Rosales-Quintero, A.; Rodriguez-Leon, A.; Ruiz-Valdiviezo, V.M.; Servin-Martinez, A. Characterization of Thermophilic Microorganisms in the Geothermal Water Flow of El Chichón Volcano Crater Lake. Water 2020, 12, 2172. https://doi.org/10.3390/w12082172
Ovando-Chacon SL, Tacias-Pascacio VG, Ovando-Chacon GE, Rosales-Quintero A, Rodriguez-Leon A, Ruiz-Valdiviezo VM, Servin-Martinez A. Characterization of Thermophilic Microorganisms in the Geothermal Water Flow of El Chichón Volcano Crater Lake. Water. 2020; 12(8):2172. https://doi.org/10.3390/w12082172
Chicago/Turabian StyleOvando-Chacon, Sandy Luz, Veymar Guadalupe Tacias-Pascacio, Guillermo Efren Ovando-Chacon, Arnulfo Rosales-Quintero, Abelardo Rodriguez-Leon, Victor Manuel Ruiz-Valdiviezo, and Alberto Servin-Martinez. 2020. "Characterization of Thermophilic Microorganisms in the Geothermal Water Flow of El Chichón Volcano Crater Lake" Water 12, no. 8: 2172. https://doi.org/10.3390/w12082172
APA StyleOvando-Chacon, S. L., Tacias-Pascacio, V. G., Ovando-Chacon, G. E., Rosales-Quintero, A., Rodriguez-Leon, A., Ruiz-Valdiviezo, V. M., & Servin-Martinez, A. (2020). Characterization of Thermophilic Microorganisms in the Geothermal Water Flow of El Chichón Volcano Crater Lake. Water, 12(8), 2172. https://doi.org/10.3390/w12082172

